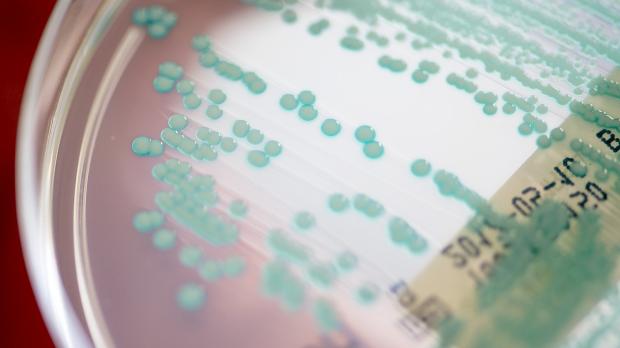

Straßburg (dpa)
Plan für strengere Antibiotika-Regeln bei Tieren fällt durch

Weil kein Antibiotikum mehr bei ihnen wirkt, sterben in der EU jedes Jahr Zehntausende. Um die Ausbreitung resistenter Keime aufzuhalten, sollen weniger Antibiotika an Tiere gehen. Doch eine Initiative dazu scheiterte nun in Straßburg.
Das EU-Parlament hat Pläne abgelehnt, fünf bestimmte Antibiotikagruppen für den Einsatz beim Menschen zu reservieren und bei Tieren weitgehend zu verbieten.
Die Abgeordneten lehnten am Donnerstag in Straßburg ein entsprechendes Vorhaben des grünen EU-Abgeordneten Martin Häusling ab. Nun dürften in der EU andere Antibiotika für Tiere gesperrt werden - welche, ist unklar. Die Bundesärztekammer kritisierte die Entscheidung scharf als vertane Chance. Tierärzte und CDU-Abgeordnete begrüßten dagegen das Votum.
Der Präsident der Bundesärztekammer, Klaus Reinhardt, sagte der Deutschen Presse-Agentur: „Sehenden Auges steuert Europa auf Zeiten zu, in denen es keine lebensrettenden Reserveantibiotika mehr gibt.“ Dabei wäre es ein Leichtes gewesen, Schlupflöcher zu schließen, um den Einsatz von Antibiotika in der Tierhaltung deutlich spürbar zu begrenzen und so die menschliche Gesundheit vor der Entwicklung resistenter Erreger zu schützen. „Die Entscheidung der Abgeordneten kann unter Umständen tatsächlich Menschenleben kosten.“
Auch Häusling sagte: „Es ist ein ganz schlechter Tag für die Humanmedizin.“ Es sei aber auch ein schlechter Tag für Hunde- und Katzenhalter. Der Grünen-Abgeordnete und der Umweltausschuss des EU-Parlaments hatten erreichen wollen, dass fünf Antibiotikagruppen vor allem Menschen vorbehalten sein sollen, aber in Ausnahmefällen an einzelne kranke Tiere verabreicht werden dürfen. Ziel war, den massenhaften Einsatz dieser Stoffe in der Tiermast zu beenden, um Antibiotikaresistenzen vorzubeugen.
Die Vorschläge hatten Protest beim Verband praktizierender Tierärzte ausgelöst. Dieser befürchtete, dass auch Haustiere künftig nicht mehr adäquat mit Antibiotika behandelt werden könnten. Er hatte eine Unterschriftenaktion gestartet. Zahlreiche Tierhalter, die um die medizinische Versorgung ihrer Vierbeiner fürchteten, unterzeichneten diesen. Verbandsgeschäftsführer Heiko Färber zeigte sich erfreut über das Abstimmungsergebnis: „Wir glauben, dass das der richtige Weg ist, um den Kampf gegen antimikrobielle Resistenzen anzugehen.“
Nun bleibt es bei den ursprünglichen Plänen der EU-Kommission. Diese will ebenfalls Antibiotika benennen, die nur für Menschen erlaubt sein sollen. Allerdings will die Brüsseler Behörde bislang keine konkreten Stoffe nennen, die auf die Liste von Reserveantibiotika kommen sollen. Stattdessen präsentierte sie Kriterien für deren Auswahl: etwa eine hohe Bedeutung für die menschliche Gesundheit und ein „nicht-essenzieller“ Bedarf in der Tiermedizin.
Reserveantibiotika sind Medikamente, die bei Infektionskrankheiten verwendet werden, wenn normale Antibiotika nicht mehr wirken. Ziel ist ein möglichst restriktiver Einsatz dieser Mittel, um ihre Wirksamkeit durch sich entwickelnde Resistenzen nicht zu gefährden. Der Grund: Je mehr ein Antibiotikum eingesetzt wird, desto eher setzen sich resistente Erreger-Subtypen durch. Solche Resistenzen sind gefürchtet: Laut der EU-Kommission sterben jedes Jahr in der EU 33.000 Menschen, weil Antibiotika bei ihnen nicht mehr wirken.
Schätzungen zufolge würden weltweit 66 Prozent aller Antibiotika für landwirtschaftliche Nutztiere verwendet und nicht für Menschen, erklärte Häusling. In Mastbetrieben würden immer noch auch gesunde Tiere über Futter oder Wasser mit Antibiotika behandelt, wenn es in dem Stall kranke Tiere gebe. Resistente Keime aus den Ställen können etwa über Fleisch zum Menschen gelangen.
Welche Stoffe am Ende auf die EU-Liste der Reserveantibiotika kommen, muss die Kommission nach Angaben von Häuslings Büro bis zum 28. Januar 2022 klarstellen. Diese Mittel sollen dann aber aller Voraussicht nach wirklich nur für Menschen erlaubt sein - eine Einzelbehandlung kranker Haustiere, wie Häusling sie gefordert hatte, schloss die Kommission zuletzt aus. Damit habe sich der Tierärzte-Verband ins eigene Knie geschossen, sagte der Grünen-Abgeordnete.
Er bemängelte eine seiner Meinung nach unredliche Kampagne des Verbands - auch gegen ihn persönlich. Es sei unverständlich, dass die Interessen der Tierärzte und der Agrarlobby nun offenbar höher gewichtet würden als die der Humanmediziner, die sich hinter sein Vorhaben gestellt hätten. „Man kann doch nicht den Schutz von Meerschweinchen mit der Humanmedizin gleichstellen.“ Laut dem SPD-Abgeordneten Tiemo Wölken ist die Entscheidung des EU-Parlaments „ein Lobby-Sieg, der mit Falschinformationen errungen wurde“.
Der Geschäftsführer des Tierärzte-Verbands, Färber, wies die Vorwürfe zurück, eine Fake-News-Kampagne geführt zu haben. Sein Verband sei stets zu Gesprächen bereit gewesen und ja ebenfalls dafür, den Einsatz von Antibiotika zu reduzieren. Aber mit den Plänen Häuslings habe die Gefahr bestanden, dass zu viele Medikamente für Tiere weggefallen wären.
Die Gruppenbehandlung von Nutztieren sei überdies bislang nicht zu ersetzen - jedenfalls nicht, ohne den Tod vieler Tiere in Kauf zu nehmen, sagte Färber. Ob man das wolle, das könne man nicht nebenher entscheiden. Nach den Anschuldigungen Häuslings würden nun viele Tierärzte in ihren Praxen von aufgebrachten Bürgern angefeindet.
Norbert Lins (CDU), Vorsitzender des Agrarausschusses im EU-Parlament, hatte vorab ebenfalls die Pläne von Häusling kritisiert. Dessen Einspruch gegen das Vorgehen der EU-Kommission hätte letztlich Lösungen verzögert, erklärte er. „Der Vorschlag der Europäischen Kommission ist wissenschaftsbasiert und verhältnismäßig.“ Er stelle „bereits eine Verringerung der in der Tiermedizin verfügbaren Antibiotika und einen verbesserten Schutz vor Antibiotikaresistenz für den Menschen dar“.
© dpa-infocom, dpa:210916-99-244178/4